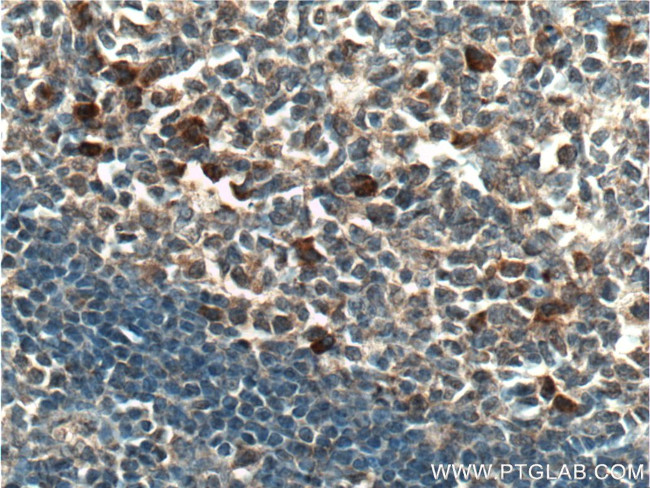
CLEC16A Antibody in Immunohistochemistry (Paraffin) (IHC (P))

Search
Proteintech
CLEC16A Polyclonal Antibody
{{$productOrderCtrl.translations['antibody.pdp.commerceCard.promotion.promotions']}}
{{$productOrderCtrl.translations['antibody.pdp.commerceCard.promotion.viewpromo']}}
{{$productOrderCtrl.translations['antibody.pdp.commerceCard.promotion.promocode']}}: {{promo.promoCode}} {{promo.promoTitle}} {{promo.promoDescription}}. {{$productOrderCtrl.translations['antibody.pdp.commerceCard.promotion.learnmore']}}
产品信息
26257-1-AP
种属反应
宿主/亚型
分类
类型
抗原
偶联物
形式
浓度
规格
纯化类型
保存液
内含物
保存条件
运输条件
产品详细信息
Immunogen sequence: MFGRSRSWV GGGHGKTSRN IHSLDHLKYL YHVLTKNTTV TEQNRNLLVE TIRSITEILI WGDQNDSSVF DFFLEKNMFV FFLNILRQKS GRYVCVQLLQ TLNILFENIS HETSLYYLLS NNYVNSIIVH KFDFSDEEIM AYYISFLKTL SLKLNNHTVH FFYNEHTNDF ALYTEAIKFF NHPESMVRIA VRTITLNVYK VDNQAMLHYI RDKTAVPYFS NLVWFIGSHV IELDDCVQTD EEHRNRGKLS DLVAEHLDHL HYLNDILIIN CEFLNDVLTD HLLNRLFLPL YVYSLENQDK GGERPKISLP VSLYLLSQVF LIIHHAPLVN SLAEVILNGD LSEMYAKTEQ D (1-350 aa encoded by BC112897)
靶标信息
This gene encodes a member of the C-type lectin domain containing family. Single nucleotide polymorphisms in introns of this gene have been associated with diabetes mellitus, multiple sclerosis and rheumatoid arthritis. Multiple transcript variants encoding different isoforms have been found for this gene.
仅用于科研。不用于诊断过程。未经明确授权不得转售。
篇参考文献 (0)
生物信息学
蛋白别名: C-type lectin domain family 16 member A; MGC111457; Protein CLEC16A
基因别名: 4932416N17Rik; CLEC16A; curt; Gop-1; KIAA0350; mKIAA0350
UniProt ID: (Human) Q2KHT3, (Mouse) Q80U30
Entrez Gene ID: (Human) 23274, (Mouse) 74374